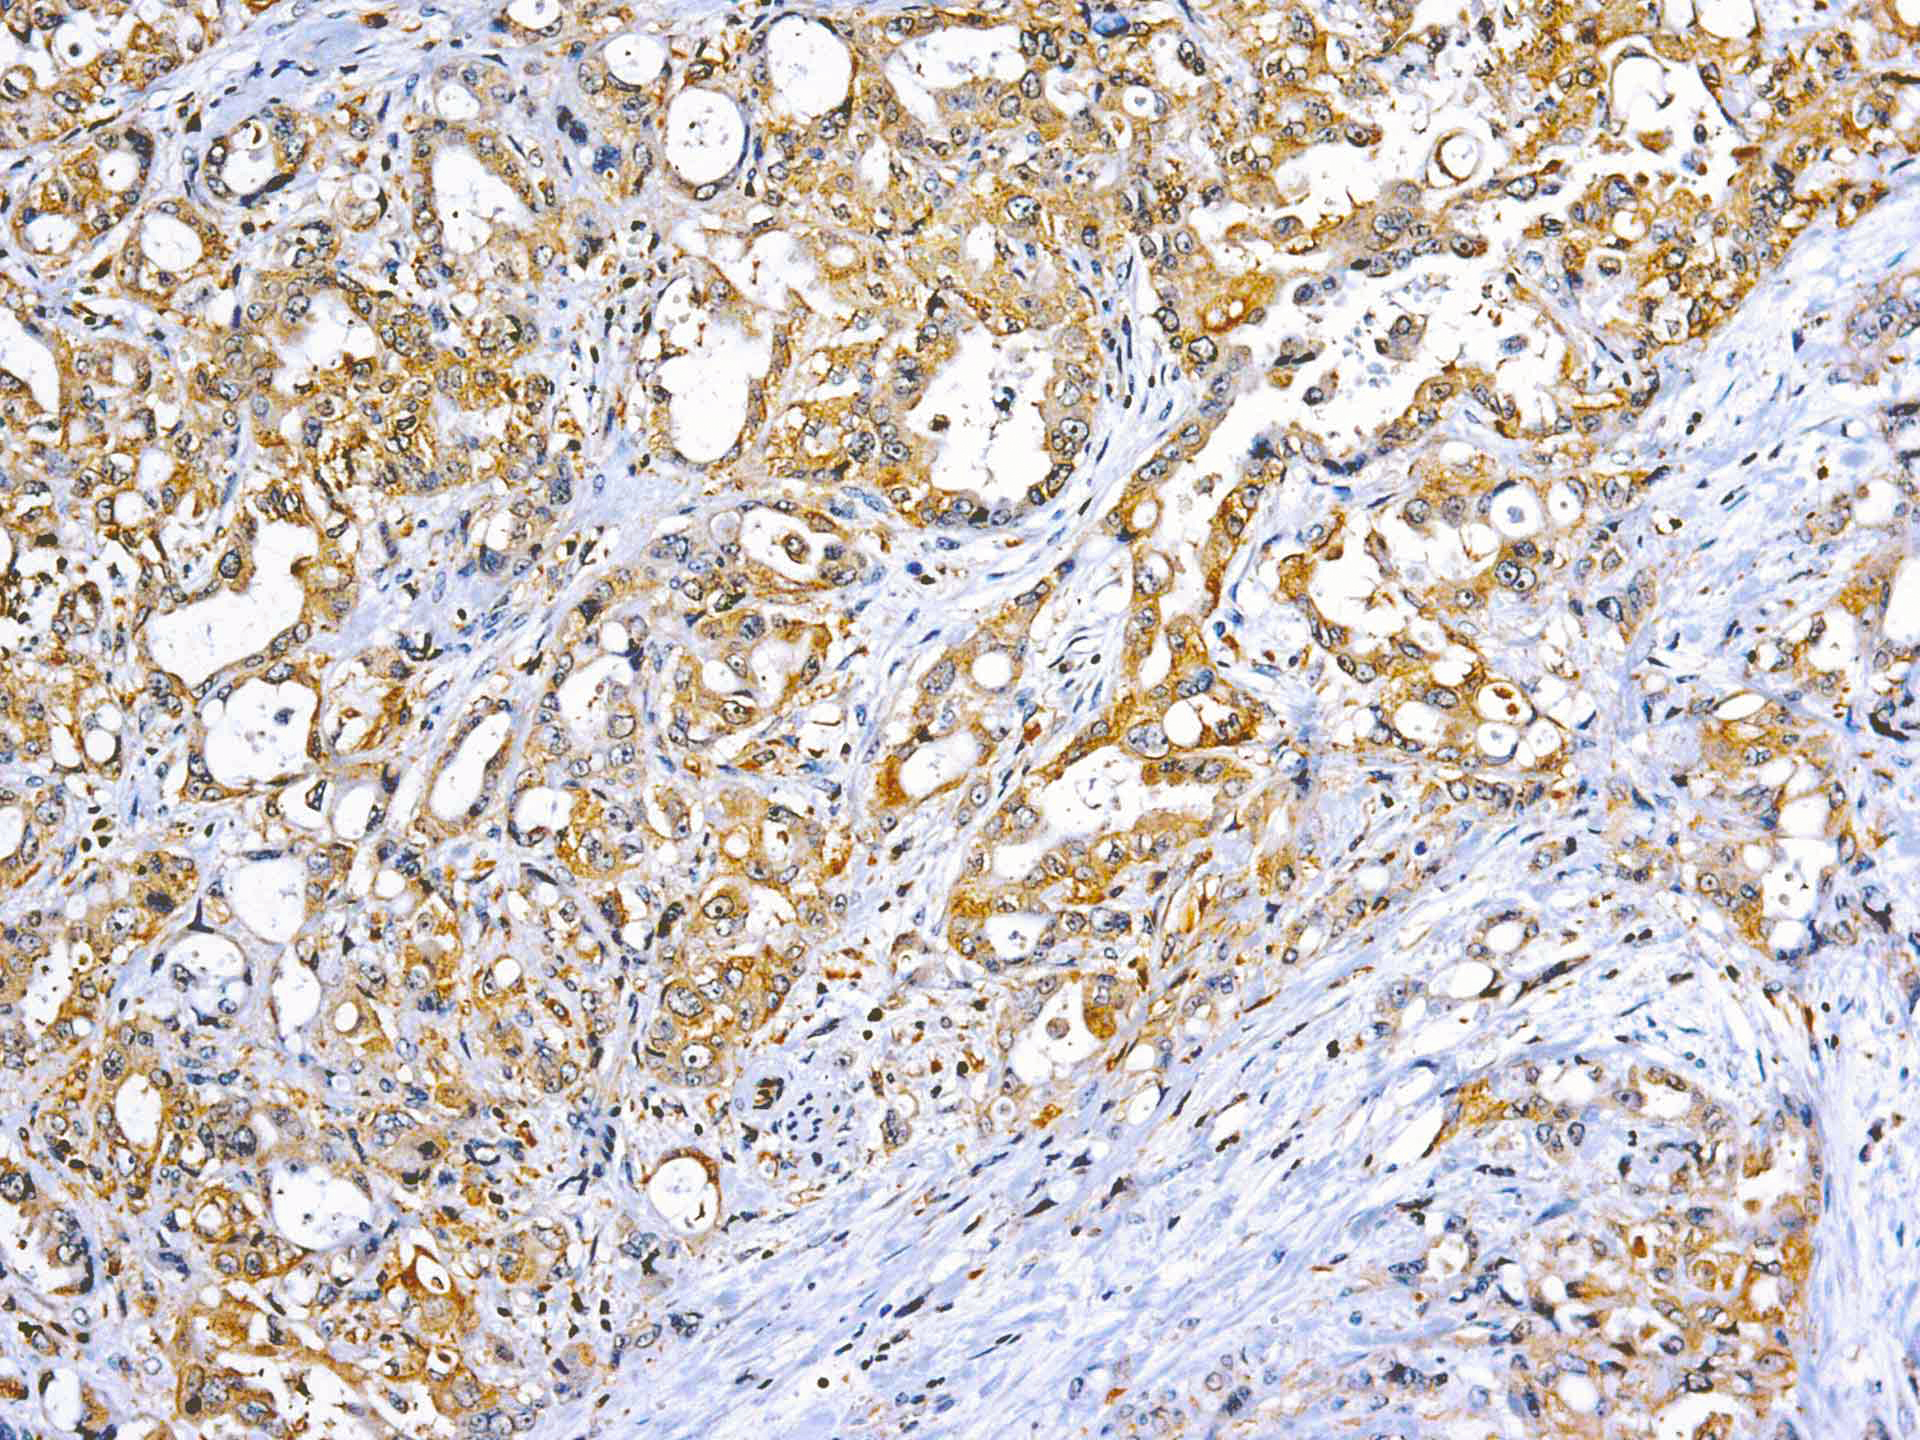

This MAb recognizes human 17-26kDa protein, which is identified as cytokine TNF-α (Tumor Necrosis Factor-alpha). Monomeric human TNF-α is a 157 amino acid protein (non-glycosylated) with a reported molecular weight of 17 kDa and can be expressed as a free molecule, also TNF-α is generated as a precursor form called transmembrane TNF-α can be expressed as a cell surface type II polypeptide consisting of 233 amino acid residues molecular weight 26 kDa. TNF-α is an important cell-signaling component of the immune system. It is a protein secreted by LPS stimulated macrophages, and causes tumor necrosis when injected into tumor bearing mice. TNF-α is currently being evaluated in treatment of certain cancers and AIDS Related Complex.
TNF-alpha (Tumor Necrosis Factor alpha)
SKU: Mob502-
Categories: Primary Antibodies, IVD - For U.S. Market, IVD - Outside U.S. Market
Tags: Concentrated, T
Description
Additional information
| Catalog No. | Mob502 Concentrated, PDM230 Prediluted |
|---|---|
| Clone | DBM15.28 |
| Isotype | IgM, kappa |
| Immunogen | Recombinant full-length human TNF-alpha protein |
| Species | Mouse |
| Cellular Localization | Cytoplasmic and extracellular (secreted) |
| Positive Control Tissue | Colon, Histiocytoma, Pancreas |
| Pretreatment | EDTA Buffer pH 8.0 |
| Incubation & Temperature | 30 min @ RT |
| Intended Use | IVD |
| Detection System | FFPE |
| Description/Type | Mouse Monoclonal Antibody |
| Format | Purified immunoglobulin |
DATASHEETS & SDS
DATASHEETS & SDS
| Download Datasheet |
| Download SDS Sheet – OSHA |
REFERENCES
REFERENCES
- Bradley JR. TNF-mediated inflammatory disease. J Pathol 2008;214:149-60.
- Pennica D, et al. Human tumor necrosis factor: precursor structure, cDNA cloning, expression, and homology to lymphotoxin.Nature 1984;312:724-9.
- Shealy DJ, et al.. Anti-TNF antibodies: lessons from the past,roadmap for the future. Handb Exp Pharmacol. 2008;(181):101-29.
- Carswell EA, et al. An endotoxin-induced serum factor that causes necrosis of tumors. PNAS (USA) 1975, 72:3666–3670.
- Bebok Z; et al. Prognostic relevance of transforming growth factor alpha (TGF-alpha) and tumor necrosis factor alpha (TNF-alpha) detected in breast cancer tissues by immunohistochemistry. Breast Cancer Research and Treatment, 1994, 29(3):229-35.
Reviews (0)
Only logged in customers who have purchased this product may leave a review.

Reviews
There are no reviews yet.